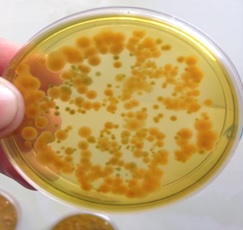
Cấy khuẩn trên đĩa thạch Cấy khuẩn trên đĩa thạch

Ao tôm có 6 dấu hiệu này, phải nhanh chóng xử lý kẻo tôm bị phân trắng
Hiện nay, việc điều trị phân trắng cho tôm có rất nhiều phương pháp khác nhau, ví dụ như: dùng kháng sinh, thuốc tây, thuốc thú y,.. Tuy nhiên, cũng có rất nhiều trường hợp trị phân trắng không khỏi hoặc trị phân trắng đã khỏi nhưng tôm lại không lớn, ốp thân và bị mất ruột,..
Bên cạnh đó, với những ao tôm bị phân trắng, tôm thường nhiễm kép hoặc đa nhiễm với nhiều tác nhân khác nhau như: Vi khuẩn, EHP, tảo độc, ký sinh trùng, ngoại ký sinh, nấm,..(Đặng Thị Hoàng Oanh và ctv., 2008). Từ đó, làm cho việc xác định các nguyên gây bệnh trở nên rất khó khăn và phức tạp.
6 dấu hiệu cần nhanh chóng xử lý để đàn tôm không bị phân trắng
Ở Việt Nam, phân trắng xuất hiện trên tôm lần đầu tiên vào năm 1998, từ khu vực Quảng Bình - Ninh Thuận. Đến 2006, bệnh này có mặt tại ĐBSCL. Bệnh phân trắng xuất hiện nhiều thường vào giai đoạn tôm từ 30-60 ngày tuổi.
1. Gan tôm mờ nhạt hoặc phần cuối ruột tôm (trên hậu môn) xuất hiện “hạt mủ” màu trắng
Gan tôm có biểu hiện mờ nhạt Ruột tôm xuất hiện hạt mủ (mủ đuôi)
2. Ao nuôi tôm có nấm, tảo lam hoặc tảo giáp mật độ cao.
Sàn cho tôm ăn bị nhiễm nấm Tảo tàn trong ao tôm 40 ngày
3. Môi trường nước ao tôm có các nhóm vi khuẩn Vibrio Harveyi, V. vulnificus,..
Cấy khuẩn trên đĩa thạch
4. Mưa đột ngột sau đó nắng gắt, ruột bị xoắn, bị lỏng và tôm giảm ăn (30-50%)
Ruột tôm bị xoắn Ruột tôm bị lỏng
5. Môi trường nước và tôm nuôi xuất hiện ký sinh trùng: Vermiform hoặc Gegarine
Gegarine trong ruột tôm Vermiform trong gan tôm
6. Đáy ao tôm có biểu hiện dơ, bùn hôi, nhớt bạt và nước ao lợn cợn,..
Đáy ao tôm bị dơ và có mùi hôi Nước ao tôm có cợn nhiều do tảo tàn
Giải pháp trị phân trắng trên tôm an toàn và hiệu quả
Phác đồ Trị phân trắng cho tôm
Bước 1: Vào 3 ngày đầu trộn
- 60% lượng thức ăn với thảo dược đường ruột cho tôm O’care từ 5-10ml/kg (tuỳ theo size tôm & sức khỏe đàn tôm).
- 40% thức ăn còn lại trộn CEFOTAXIM (99%) 1g/kg.
- Thay nước 50% và tiến hành diệt khuẩn, nấm.
- Thời gian: thực hiện lúc 9-10 giờ sáng, sử dụng 2 liều cách nhau 24 giờ.
- Liều lượng: 1 gói diệt khuẩn nấm MB01 cho 1000m3 nước ao.
Bước 2: Ngày thứ 4 trở đi trộn
100% kháng thể K-WE 10g/kg + thảo dược gan BETA 1.3 – 1.6 10g/kg (đến khi tôm hồi phục lại hoàn toàn).
Bên cạnh đó định kỳ:
- Thường xuyên kiểm tra mật độ khuẩn, nấm, ký sinh trùng trong ao nuôi.
- Quản lý độ trong của nước (lợn cợn), mật độ khuẩn trong ao tôm và độ sạch của đáy ao bằng chế phẩm sinh học: Men vi sinh dạng viên PRO4000X (nhập khẩu trực tiếp Hoa Kỳ).
Men vi sinh dạng viên PRO4000X xử lý môi trường nước ao nuôi tôm
Trên đây là 6 dấu hiệu cần nhanh chóng xử lý để đàn tôm không bị phân trắng, mọi thắc mắc về kỹ thuật hay thông tin sản phẩm trong bài, bà con vui lòng liên hệ qua 0967 737 626 để được các kỹ thuật viên của công ty trực tiếp giải đáp.
Chúc bà con vụ nuôi thành công.

Xem thêm